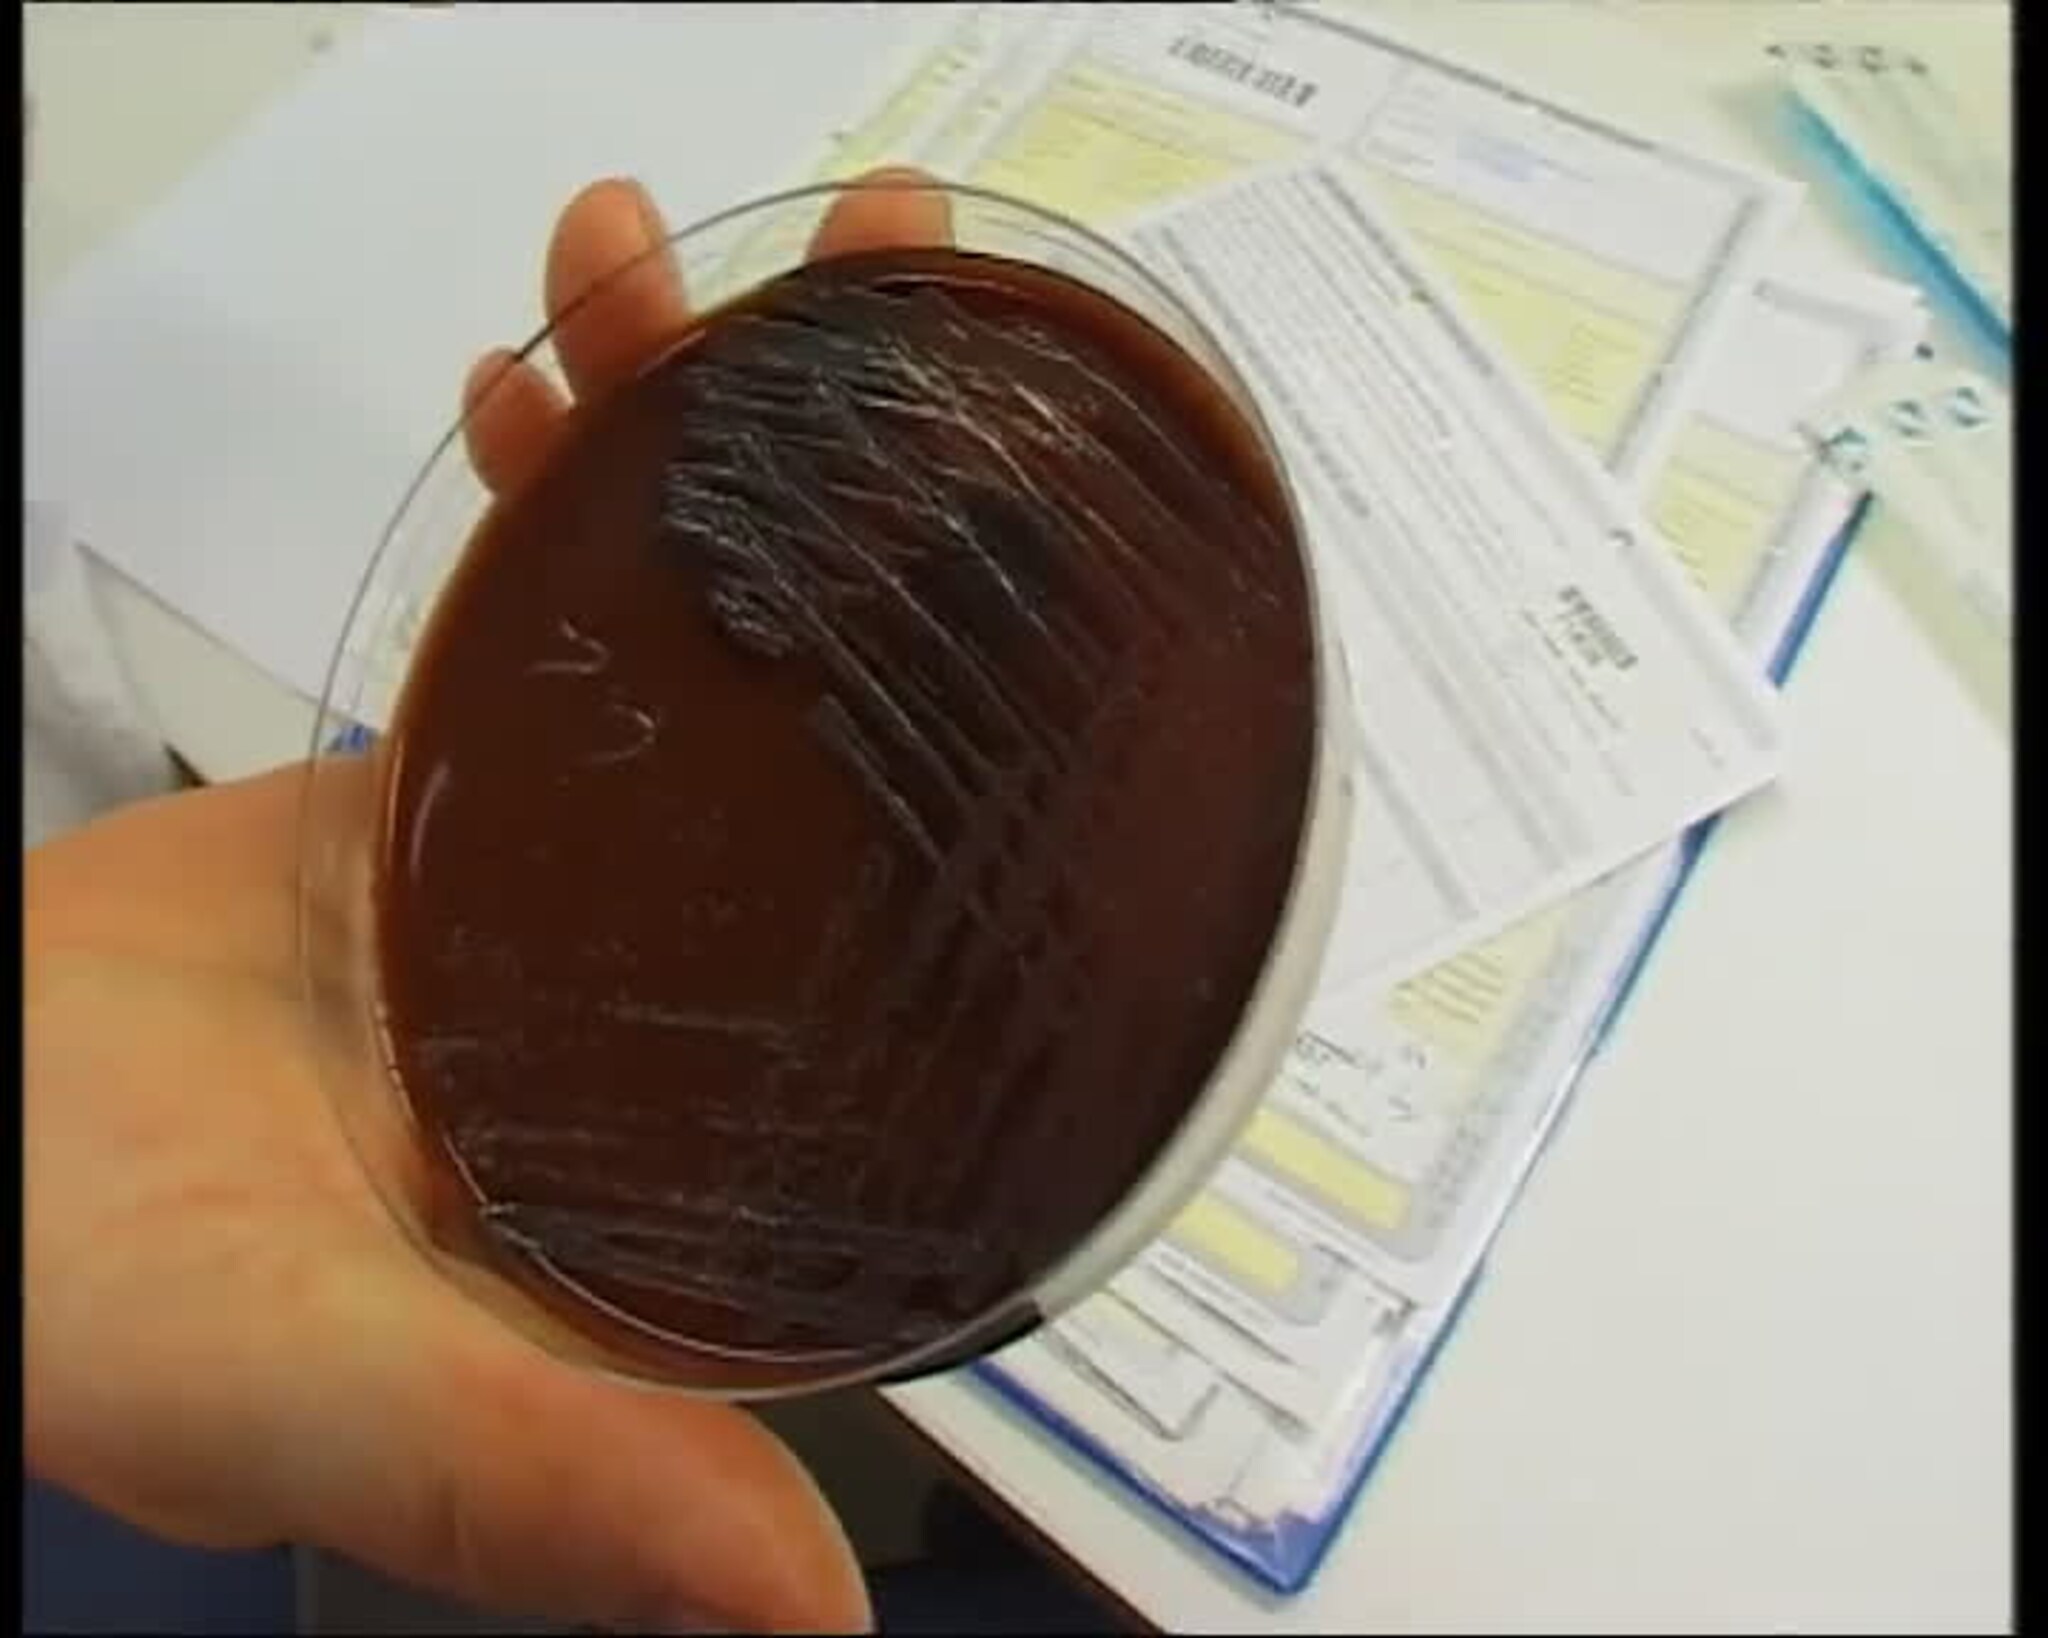
TVSør 20.01.2004

TVSør 20.01.2004
* 0.57: Dentosept Rapport * 2.11: Dent-o-sept * 2.31: Dent-o-sept Reaksjoner * 4.29: Vigeland Metal * 4.59: Sør * 5.29: Nytt forslag kan løse striden om autopassbrikka * 5.44: Drotningborg * 7.12: Sør * 8.12: Gard sentral i erstatningene etter forliset i bergen * 8.27: Saluttering * 9.38: Glatta * 11.43: Sløgedal CD * 16.28: Været * 19.58: Våg * 22.03: Skøytegall på Evje * 24.44: Bordtennis * 040120-vipers i oppløsning Fredag ble han overraskende ansatt som ny trener i Våg Vipers. Nå venter en tøff oppgave for Arnfinn Haukom Olsen som skal ta over et håndballag som er i ferd med å gå i oppløsning. I innslaget: Jim Rune Bjorvand/Reporter; Arnfinn Haukom Olsen/Trener, Våg Vipers; Peder Langfeldt/ Assistenttrener, KIF; Michael Nøvik/Nestformann, Våg Vipers; Erik Augestad/Tidligere KIF-trener * Vigeland metal sier opp 13 personer ved Vigeland metal Refinety på Vennesla mister jobben som følge av reduksjonen bedriften må gjennomføre. Samtlige har fått tilbud om sluttpakke, 11 har tatt imot dette og sagt opp, mens situasjonen er uavklart for 2 av de overtallinge. Årsaken til nedbemanningen ved vennesla-bedriften er svikt i markedet, og at bedriften mistet en stor leveranse de var forespeilet. I innslaget: bilder * Bomstriden løst? Striden om hvordan abonnenter skal passere bompengeringen i Kristiansand, kan bli løst på et ekstraordinært styremøte i Bomselskapet torsdag. Daglig leder i selskapet mener, i følge NRK Sørlandet, at alle uten autopassbrikke må vise kvittering for abonnement ved passering. Men styrelederen vil i stedet foreslå at alle abonnenter passerer i samme fil. Så må det bli opp til selskapet å finne ut i ettertid hvem som har abonnement. * Ungdommens Kulturmønstring Høyskolen i Agder har et spennende samarbeid med Ungdommens Kultur Mønstring i Vest-Agder. 6 studenter skal stå for den praktiske gjennomføringen av mønstringen og nå arbeider de på spreng for at alt skal gå så bra som mulig. I innslaget: Cheryl Macdonald, reporter; Guro Schei Johansson, HiA-student, drama; Foto, Cheryl Macdonald * Det var den 23 år gamle Annette Ariansen fra Lyngdal som omkom i snøscooterulykken i Sogndalen søndag ettermiddag. Kvinnen mistet kontrollen over den kraftige snøscooteren og kjørte inn i noen trær ved Sogndalselva på Volleberg. Lensmannen i Søgne og Songdalen vil i løpet av uken avhøre vitner til ulykken.--- I innslaget: Nyhetene 19.01.04 * Dent-o-sept-reaksjoner Ikke i sine villeste fantasier hadde helevesenet trodd at en så stor skandale som Dent-o-sept-saken kunne ramme Norge. Det sier fylkeslegen i Vest-Agder Kristian Hagestad. Saken har fått store konsekvenser både for legemiddelprodusenter, helsetilsyn og sykehusene. I innslaget: Christian Wulff, reporter; Kristian Hagestad; Knut Bertnes, medisinsk rådgiver Sørlandet sykehus Kristiansand; Rano-; Foto: Pål Jørgensen * 50 døde av Dent o sept fra Snøgg 50 mennesker døde trolig som følge av de infiserte Dent-o-sept munnpenslene fra Snøgg industrier i Kristiansand. I dag kom sluttrapporten etter skandalen. I innslaget: Pål Jørgensen, reporter; Kristian Fossheim, direktør Snøgg industri; Foto: Pål Jørgensen